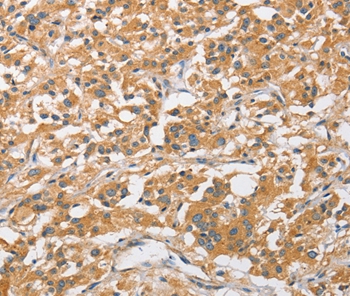

ARL8A Antibody (aa116-142, Biotin)
LS-C251734
ApplicationsFlow Cytometry, Western Blot, ELISA, ImmunoHistoChemistry
Product group Antibodies
TargetARL8A
Overview
- SupplierLifeSpan BioSciences
- Product NameARL8A Antibody (aa116-142, Biotin)
- Delivery Days Customer23
- Application Supplier NoteThe applications listed have been tested for the unconjugated form of this product. Other forms have not been tested.
- ApplicationsFlow Cytometry, Western Blot, ELISA, ImmunoHistoChemistry
- Applications SupplierELISA, Flo, IHC, WB The applications listed have been tested for the unconjugated form of this product. Other forms have not been tested.
- CertificationResearch Use Only
- ClonalityPolyclonal
- ConjugateBiotin
- Estimated Purity...
- Gene ID127829
- Target nameARL8A
- Target descriptionADP ribosylation factor like GTPase 8A
- Target synonymsADP-ribosylation factor-like 10B; ADP-ribosylation factor-like 8A; ADP-ribosylation factor-like protein 8A; ARL10B; GIE2; GTPase indispensable for equal segregation of chromosomes 2; novel small G protein indispensable for equal chromosome segregation 2
- HostRabbit
- IsotypeIgG
- Storage Instruction-20°C,2°C to 8°C
- UNSPSC12352203